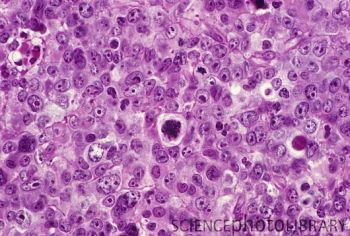

导读:中国科学技术大学生命科学学院吴缅教授研究组与澳大利亚纽卡斯尔大学张旭东教授合作,通过表观遗传学的研究手段,发现非编码RNA miR-149*参与黑色素瘤的发生和发展,揭示了一种p53依赖型的非编码微小RNA促进黑色素瘤发生的新机理。

p53被认为是迄今为止所发现的最为重要的肿瘤抑制因子,它在人类50%以上的肿瘤细胞中都发生了各种不同程度的突变。然而在黑色素瘤中,p53在多数情况下呈野生型,并且高量表达,并不具有抑制肿瘤的能力,甚至在某些药物作用下,p53还起到保护肿瘤的作用。p53在黑色素瘤中的这一“反常”现象长期困惑着这一领域的研究人员。(更多)

黑色素细胞瘤可由表皮黑色素细胞,痣细胞或真皮成黑色素细胞组成。肿瘤起源于外胚叶的神经嵴,黑色素细胞位于表皮层与基底细胞间排列,细胞产生色素后,通过树状突将黑色素颗粒输送到基底细胞和毛发内。
大多数恶性黑色素瘤的发生,是由于黑色素痣受到反复的摩擦、抓起和损伤而引起恶变,不适当的挖除和药物腐蚀等,可使良性黑色素痣转化成恶性黑色素瘤。孕期或生育年龄的妇女会使恶性黑色素瘤发展迅速,提示疾病与内分泌有关。从年龄上看,多发生在中老年人,很少数发生在青春期前。据报道:84%恶性黑色素瘤来自良性痣。据Wieeio报告,由于痣太小的缘故,许多病人患病初期都没有注意到。


正常黑色素细胞瘤变的真正原因尚不清楚,与下列因素可能有关:
(1)大气污染 氟里昂等有害物质的大量排放破坏了臭氧层,造成紫外线滤过不充分,有害的紫外线与空气中的有害物质携手共同作用于人体皮肤,造成黑素细胞异常表达,引发黑素瘤。
(2)爱美之心作怪 许多人为了追求皮肤的洁嫩而大量使用化学类化妆品,造成化学性皮肤污染,甚至有人用化学腐蚀剂去除掉皮肤上的黑痣,结果适得其反,刺激了黑素细胞的过度增殖。
(3)卫生知识缺乏 对长在足部、会阴部等易受摩擦部位的黑痣未引起足够重视,凭其长期受到挤压与摩擦,终致其发生恶性转变。
(4)滥用雌激素类药物 研究发现恶性黑色素瘤的细胞内有雌激素受体,因此,人们怀疑雌激素过量会刺激黑色素瘤的发生。
(5)免疫缺陷 随着生活水平的提高,中国人寿命明显延长。伴随年龄的增长,人体免疫功能逐渐衰退。研究发现,免疫功能低下是黑色素瘤发生的重要原因之一,所以临床上老年人黑色素瘤的发病率很高。
(6).良性黑色素斑块 即黑痣,其中交界痣最易恶变,混合痣较少,而内皮痣则极少恶变。但头皮黑色素瘤多数并非黑痣转变而来,故有人认为本病不完全与黑痣有关。
(7).种族 白人比有色人种发病率高,如美国白种人的年发病率高达42/10万,而黑人仅为0.8/10万。

以前,转移性黑色素瘤患者的10年生存率不到10%,且在治疗上还存在尚未满足的需求。最近,美国食品药品管理局(FDA)批准易普利姆玛(ipilimumab),用于治疗不可切除或转移性黑色素瘤,成为该病治疗上的一大突破。
在日前举行的美国临床肿瘤学会2011年年会上公布的两种新药能减缓肿瘤恶化,显著提高晚期黑色素瘤患者存活率,被誉为30年来皮肤癌治疗领域的最大突破。相关论文发表在《新英格兰医学》杂志上。
日本研究人员日前报告说,他们新发现了一种能够作为恶性黑色素瘤发病标志的物质,分析血液中该物质的含量可帮助尽早作出诊断。